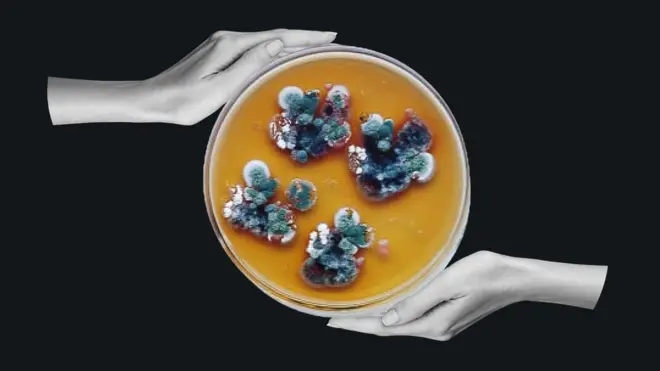
Moho

"No colecciono horrores sino pruebas del espíritu humano": Svetlana Alexievich, la Nobel de Literatura que contó como nadie el drama de Chernóbil

- Autor, Vibeke Venema
- Autor, Tatsiana Yanutsevich
- Título del autor, BBC World Service
- Tiempo de lectura: 8 min
Al día siguiente de las elecciones de 2020, que marcaron el sexto mandato consecutivo del presidente bielorruso, Svetlana Alexievich vio cómo "cientos de miles de personas" marchaban frente a su apartamento en Minsk.
"Pensé que nunca se levantarían, pero lo hicieron. Fue quizás una de las sensaciones más intensas que he experimentado en mi vida", dice la autora y ganadora del Premio Nobel de Literatura en 2015.
Parte de esa sensación era "una esperanza ingenua, pero esperanza al fin".
Alexievich se unió a las protestas contra unas elecciones consideradas amañadas y al Consejo de Coordinación encargado de preparar nuevas elecciones y una transición pacífica del poder.
Pero, poco a poco, con el paso de las semanas, la esperanza se fue apagando.
"Ahora queda claro lo románticos que fuimos", dice.

Fuente de la imagen, Twitter/@AnnLinde
Las protestas fueron brutalmente reprimidas y los miembros del Consejo de Coordinación fueron arrestados uno a uno, hasta que Alexievich, que entonces tenía 72 años, era la única a la que aún no habían detenido.
Cuando hombres enmascarados intentaron irrumpir en su departamento, varias embajadas extranjeras acudieron en su ayuda. Durante dos semanas, diplomáticos europeos y sus esposas se turnaron para vigilar la casa, pero finalmente ella no tuvo otra opción que irse.
Alexievich cuenta que gracias a que la embajadora adjunta alemana, Anna Luther, la acompañó al aeropuerto, pudo tomar un vuelo a Berlín. No se llevó casi nada consigo, con la esperanza de regresar pronto, pero ya lleva cinco años en la capital alemana y tiene pocas perspectivas de volver a casa.
Intento de utopía
Svetlana Alexievich, de 77 años, ha dedicado más de 40 años a registrar la vida de la gente de la Unión Soviética y de los Estados independientes que surgieron después de la disolución del bloque comunista. También la Segunda Guerra Mundial, la guerra soviético-afgana y el desastre nuclear de Chernóbil.
Sus libros llevan el nombre de "Voces de la Utopía", en una irónica referencia al experimento comunista que duró 70 años.
"Quería describir este intento de utopía, mostrar cómo lo vivía la gente en el interior de sus corazones y sus hogares", afirma.
Pero la realidad que describe en sus libros Alexievich dista mucho de ser utópica. Por ese motivo, sus libros llegaron a ser eliminados de los programas de estudio en Rusia y Bielorrusia. Además ha sido censurada y procesada hasta terminar en el exilio.

Fuente de la imagen, AFP via Getty Images
A nivel internacional, la historia es diferente. Los libros de Alexievich se han traducido a 52 idiomas, publicado en 55 países y le permitieron ganar el Premio Nobel de Literatura en 2015.
En su apartamento de Berlín, sobre una gran mesa de madera, se ven decenas de anotaciones sobre su próximo libro, que empezó a escribir tras los acontecimientos de 2020.
Para eso, habla con jóvenes que salieron a la calle aquel día y les pregunta qué querían y qué es aquello que los decepciona hoy.
"Quizás amamos demasiado las revoluciones. No siempre están a la altura de nuestras esperanzas… Bueno, ahora ya no apoyo las revoluciones, no apoyo el derramamiento de sangre".
La voz humana
Cuando la Unión Soviética se derrumbó en la década de 1990, "parecía que todos nos habíamos liberado del cautiverio", dice Alexievich. Sin embargo, "el hombre rojo", la encarnación del régimen soviético, no murió con el imperio.
"Está disparando en Ucrania, está sentado en el Kremlin. No, todavía no ha muerto", agrega.
En cada uno de sus libros, Alexievich entrevista a cientos de personas, combinando ingeniosamente sus testimonios en lo que ella llama "una novela en voces".
"Es un intento de convertir la vida cotidiana en literatura. Elijo obras de arte de la vida real", dice comparándolo con el método del escultor Rodin, quien decía que empezaba con un bloque de mármol y cortaba lo que no necesitaba.
"Me encanta cómo hablan los humanos", dijo en su discurso de entrega del Nobel de 2015. "Me encanta la voz humana solitaria. Es mi mayor amor y mi mayor pasión".
La reacción a su premio Nobel en Bielorrusia fue "maravillosa" y, según dice, en Minsk se acabó el champán y la gente la abrazó en las calles.
Incluso Alexander Lukashenko, un exadministrador de una granja colectiva que desde hace 31 años es presidente del país, dijo que leería sus libros, aunque ella no cree que lo haya hecho.
"Tiene una visión diferente del mundo", afirma.
Primeros años
Alexievich recuerda haber crecido en aldeas habitadas principalmente por mujeres, tras la devastación de la Segunda Guerra Mundial.
Millones de bielorrusos murieron en la guerra, y millones de los que habían luchado en Europa fueron enviados a los gulags a su regreso.
"Solo durante las bodas la gente estaba alegre, pero eran muy contadas las ocasiones, porque la mayoría de los jóvenes habían fallecido".

Fuente de la imagen, Archivo familiar de Svetlana Alexievich
Por eso, las mujeres son para Alexievich las heroínas más queridas de sus libros. Incluso su primer libro, "El rostro no femenino de la guerra" (1985), trataba sobre veteranas.
Un millón de mujeres soviéticas se ofrecieron como voluntarias para servir como soldados y médicas, pero su aporte quedó prácticamente invisibilizado hasta que Alexievich lo sacó a la luz en sus libros.
Los relatos son terribles y aterradores, pero no exentos de humor. Por ejemplo, una mujer le contó a Alexievich que una de las peores cosas de servir en el ejército era tener que usar ropa interior masculina.
La permanencia del arte
"Si no hubieran contado sus historias y yo no las hubiera grabado, todo habría desaparecido sin habernos enterado", afirma.
Tras las reformas de la perestroika de la década de 1980, el libro de Alexievich se convirtió en un éxito de ventas, con 2 millones de ejemplares publicados en ruso.
Pero su siguiente libro, "Los muchachos de zinc" (1991) generó controversia. Su nombre se debía a los ataúdes revestidos de zinc en los que se enviaban los cuerpos de los soldados soviéticos desde Afganistán.

Fuente de la imagen, Archivo familiar de Svetlana Alexievich
Alexievich había estado en Kabul como periodista. En aquella oportunidad, encontró algo hermoso en los hombres guapos en uniforme y sus armas relucientes.
Pero la guerra le desagradaba, sobre todo el hecho de ver pueblos enteros arrasados por múltiples lanzacohetes. La escritora dice que, para ella, era importante ver hasta dónde es capaz de llegar la gente.
"En general, el arte es inmoral, porque espías el dolor ajeno. Es el dolor ajeno el que te da la oportunidad de crecer".
Tras la publicación del libro, Alexievich fue llevada a juicio por veteranos y madres de soldados caídos, quienes la acusaron de difamación y profanación del honor de los soldados.
"El libro hablaba de la terrible situación a la que habían sido arrastrados sus hijos, quienes se habían convertido en asesinos. Y entonces se encontraron cara a cara con las verdades que más temían".
Oración de Chernóbil
Pero el libro que más desea que todos lean es "Oración de Chernóbil. Una crónica del futuro" (1997).
"Temo que hoy en día toda persona moderna debería saber algo sobre el átomo y sus peligros", afirma.
Teme que los ataques rusos a las centrales eléctricas ucranianas, incluidas las que suministran energía de reserva para mantener seguros los reactores nucleares, puedan causar un nuevo desastre.
La catástrofe de Chernóbil de 1986 envió nubes radiactivas hacia el norte, sobre su hogar en Minsk.
Luego pasó un tiempo en la zona de exclusión alrededor de la central dañada, entrevistando a las personas que seguían viviendo allí y compartiendo su comida, a pesar del riesgo de contaminación.
"No podía, como hacían los periodistas occidentales, escuchar todas esas historias terribles sobre cómo una hija murió, nació sin brazos, sin piernas, y luego, cuando nos invitaban a la mesa, comer un sándwich aparte", dice.

Fuente de la imagen, AFP via Getty Images
El libro de Alexievich inspiró a varios personajes de la popular miniserie de televisión de 2019 "Chernóbil", entre ellos la esposa de uno de los primeros bomberos que murió de envenenamiento por radiación, Lyudmila Ignatenko. Cuando se emitió la serie, ella se sintió molesta por el enorme interés mediático en su vida.
"Pero no hay forma de contar una historia sin entrometerse en la vida de alguien", dice Alexievich.
Y mucha gente quiere que sus historias se conozcan.
La esposa de otro bombero entrevistado por Alexievich sobornó para entrar al hospital donde su esposo agonizaba, para estar con él en sus últimos días de vida. Su dolor solo se alivió, le dijo a Alexievich, cuando hicieron el amor; "luego, guardó silencio un rato".
Para proteger a la mujer de la condena pública, Alexievich le dio un nombre falso. Pero ella la llamó por teléfono después de la publicación de la primera edición para preguntarle por qué lo había hecho.
"No quería que te hicieran daño", le dijo Alexievich. Ella respondió: "No, sufrí mucho, él sufrió mucho. Di la verdad, aunque me cueste el corazón".
A pesar del tema oscuro, el amor es un tema recurrente en los libros de Alexievich.
"Siempre he creído que escribo sobre el amor. No colecciono horrores, colecciono demostraciones del espíritu humano", dijo en 2015.
Los jueces del Nobel describieron sus obras como "un monumento al sufrimiento y la valentía en nuestro tiempo".
Este contenido fue creado como una coproducción entre Nobel Prize Outreach y la BBC.

Haz clic aquí para leer más historias de BBC News Mundo.
Suscríbete aquí a nuestro nuevo newsletter para recibir cada viernes una selección de nuestro mejor contenido de la semana.
Y recuerda que puedes recibir notificaciones en nuestra app. Descarga la última versión y actívalas.